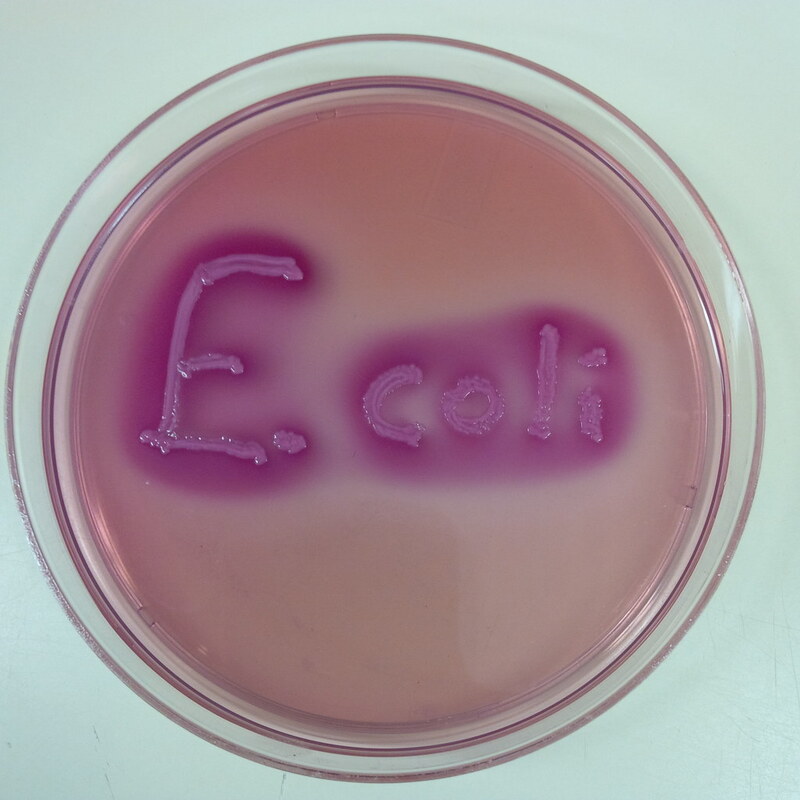
Является ли кислотность бактерий ключом к решению проблемы резистентности к противомикробным препаратам?

Снижение кислотности бактерий может помочь снизить резистентность к противомикробным препаратам.
Ученые из Эксетерского университета разработали новый метод, который позволяет измерять рН отдельных бактерий до, во время и после антибиотикотерапии.
Исследование, опубликованное в журнале mBio, закладывает основу для понимания особых свойств бактерий, которые выживают после терапии антибиотиками, что позволит разработать новые способы воздействия на них. Исследовательская группа обнаружила, что еще до лечения антибиотиками клетки Escherichia coli, выживающие после терапии, имеют более кислый внутриклеточный pH по сравнению с клональными клетками, которые уничтожаются в результате лечения антибиотиками. Эти выжившие клетки называются персистерами, поскольку они ответственны за персистирующие бактериальные инфекции и способствуют возникновению резистентности к антибиотикам.
Исследователи обнаружили механизмы, которые позволяют персистерам иметь кислый pH. Оценив генетические свойства этих клеток, они обнаружили, что два клеточных процесса, а именно метаболизм триптофана и катаболизм карбоновых кислот, отвечают за низкий уровень pH, обнаруженный у бактерий-персистеров. Стефано Пальяра, возглавляющий это исследование, сказал в интервью Since Daily:
"Наши результаты показывают, что манипулирование внутриклеточным pH представляет собой бактериальную стратегию выживания после воздействия антибиотиков. Наши новые данные позволяют предложить стратегию разработки антибиотиков, которые вмешиваются в ключевые клеточные компоненты персистеров и снижают их кислотность".
Сейчас участники этого исследования работают над тем, чтобы выяснить, является ли кислотность клеток ключевым фактором резистентности к антибиотикам у других важнейших бактериальных патогенов, таких как Pseudomonas aeruginosa и Burkholderia pseudomallei, и определить лекарственные молекулы, способные изменять рН клеток-персистеров перед началом курса лечения антибиотиками.
Olivia Goode et al. Персистеры Escherichia coli имеют более низкий внутриклеточный pH, чем восприимчивые клетки, но сохраняют свой pH в ответ на лечение антибиотиками (аннотация).
Персистирующие и жизнеспособные, но некультивируемые (VBNC) клетки - это две клональные субпопуляции, которые могут выживать при воздействии нескольких лекарственных препаратов с помощью множества предполагаемых молекулярных механизмов. В данном исследовании мы объединили микрофлюидику, хронометражную микроскопию и кодируемый плазмидой флуоресцентный репортер pH для измерения динамики внутриклеточного pH отдельных клеток персистеров, VBNC и восприимчивых клеток Escherichia coli в ответ на воздействие ампициллином. Мы обнаружили, что еще до воздействия антибиотиков персистеры имеют более низкий внутриклеточный рН, чем VBNC и восприимчивые клетки.
Затем мы изучили молекулярные механизмы, лежащие в основе наблюдаемой дифференциальной регуляции рН в клетках персистирующих E. coli, и обнаружили, что она связана с активностью фермента триптофаназы, который кодируется tnaA. Фактически, в штамме ΔtnaA мы не обнаружили различий во внутриклеточном pH между персистирующими, VBNC и восприимчивыми клетками E. coli. Цельногеномный транскриптомный анализ показал, что помимо снижения регуляции метаболизма триптофана, штамм ΔtnaA снизил регуляцию ключевых путей гомеостаза рН, включая реакцию на рН, восстановление окисления и несколько процессов катаболизма карбоновых кислот, по сравнению с уровнем экспрессии в родительском штамме.
Наше исследование проливает свет на гомеостаз рН, доказывая, что регуляция внутриклеточного рН не является однородной в пределах клональной популяции, при этом подмножество клеток демонстрирует дифференциальную регуляцию рН для выполнения специальных функций, включая выживание после терапии антибиотиками.